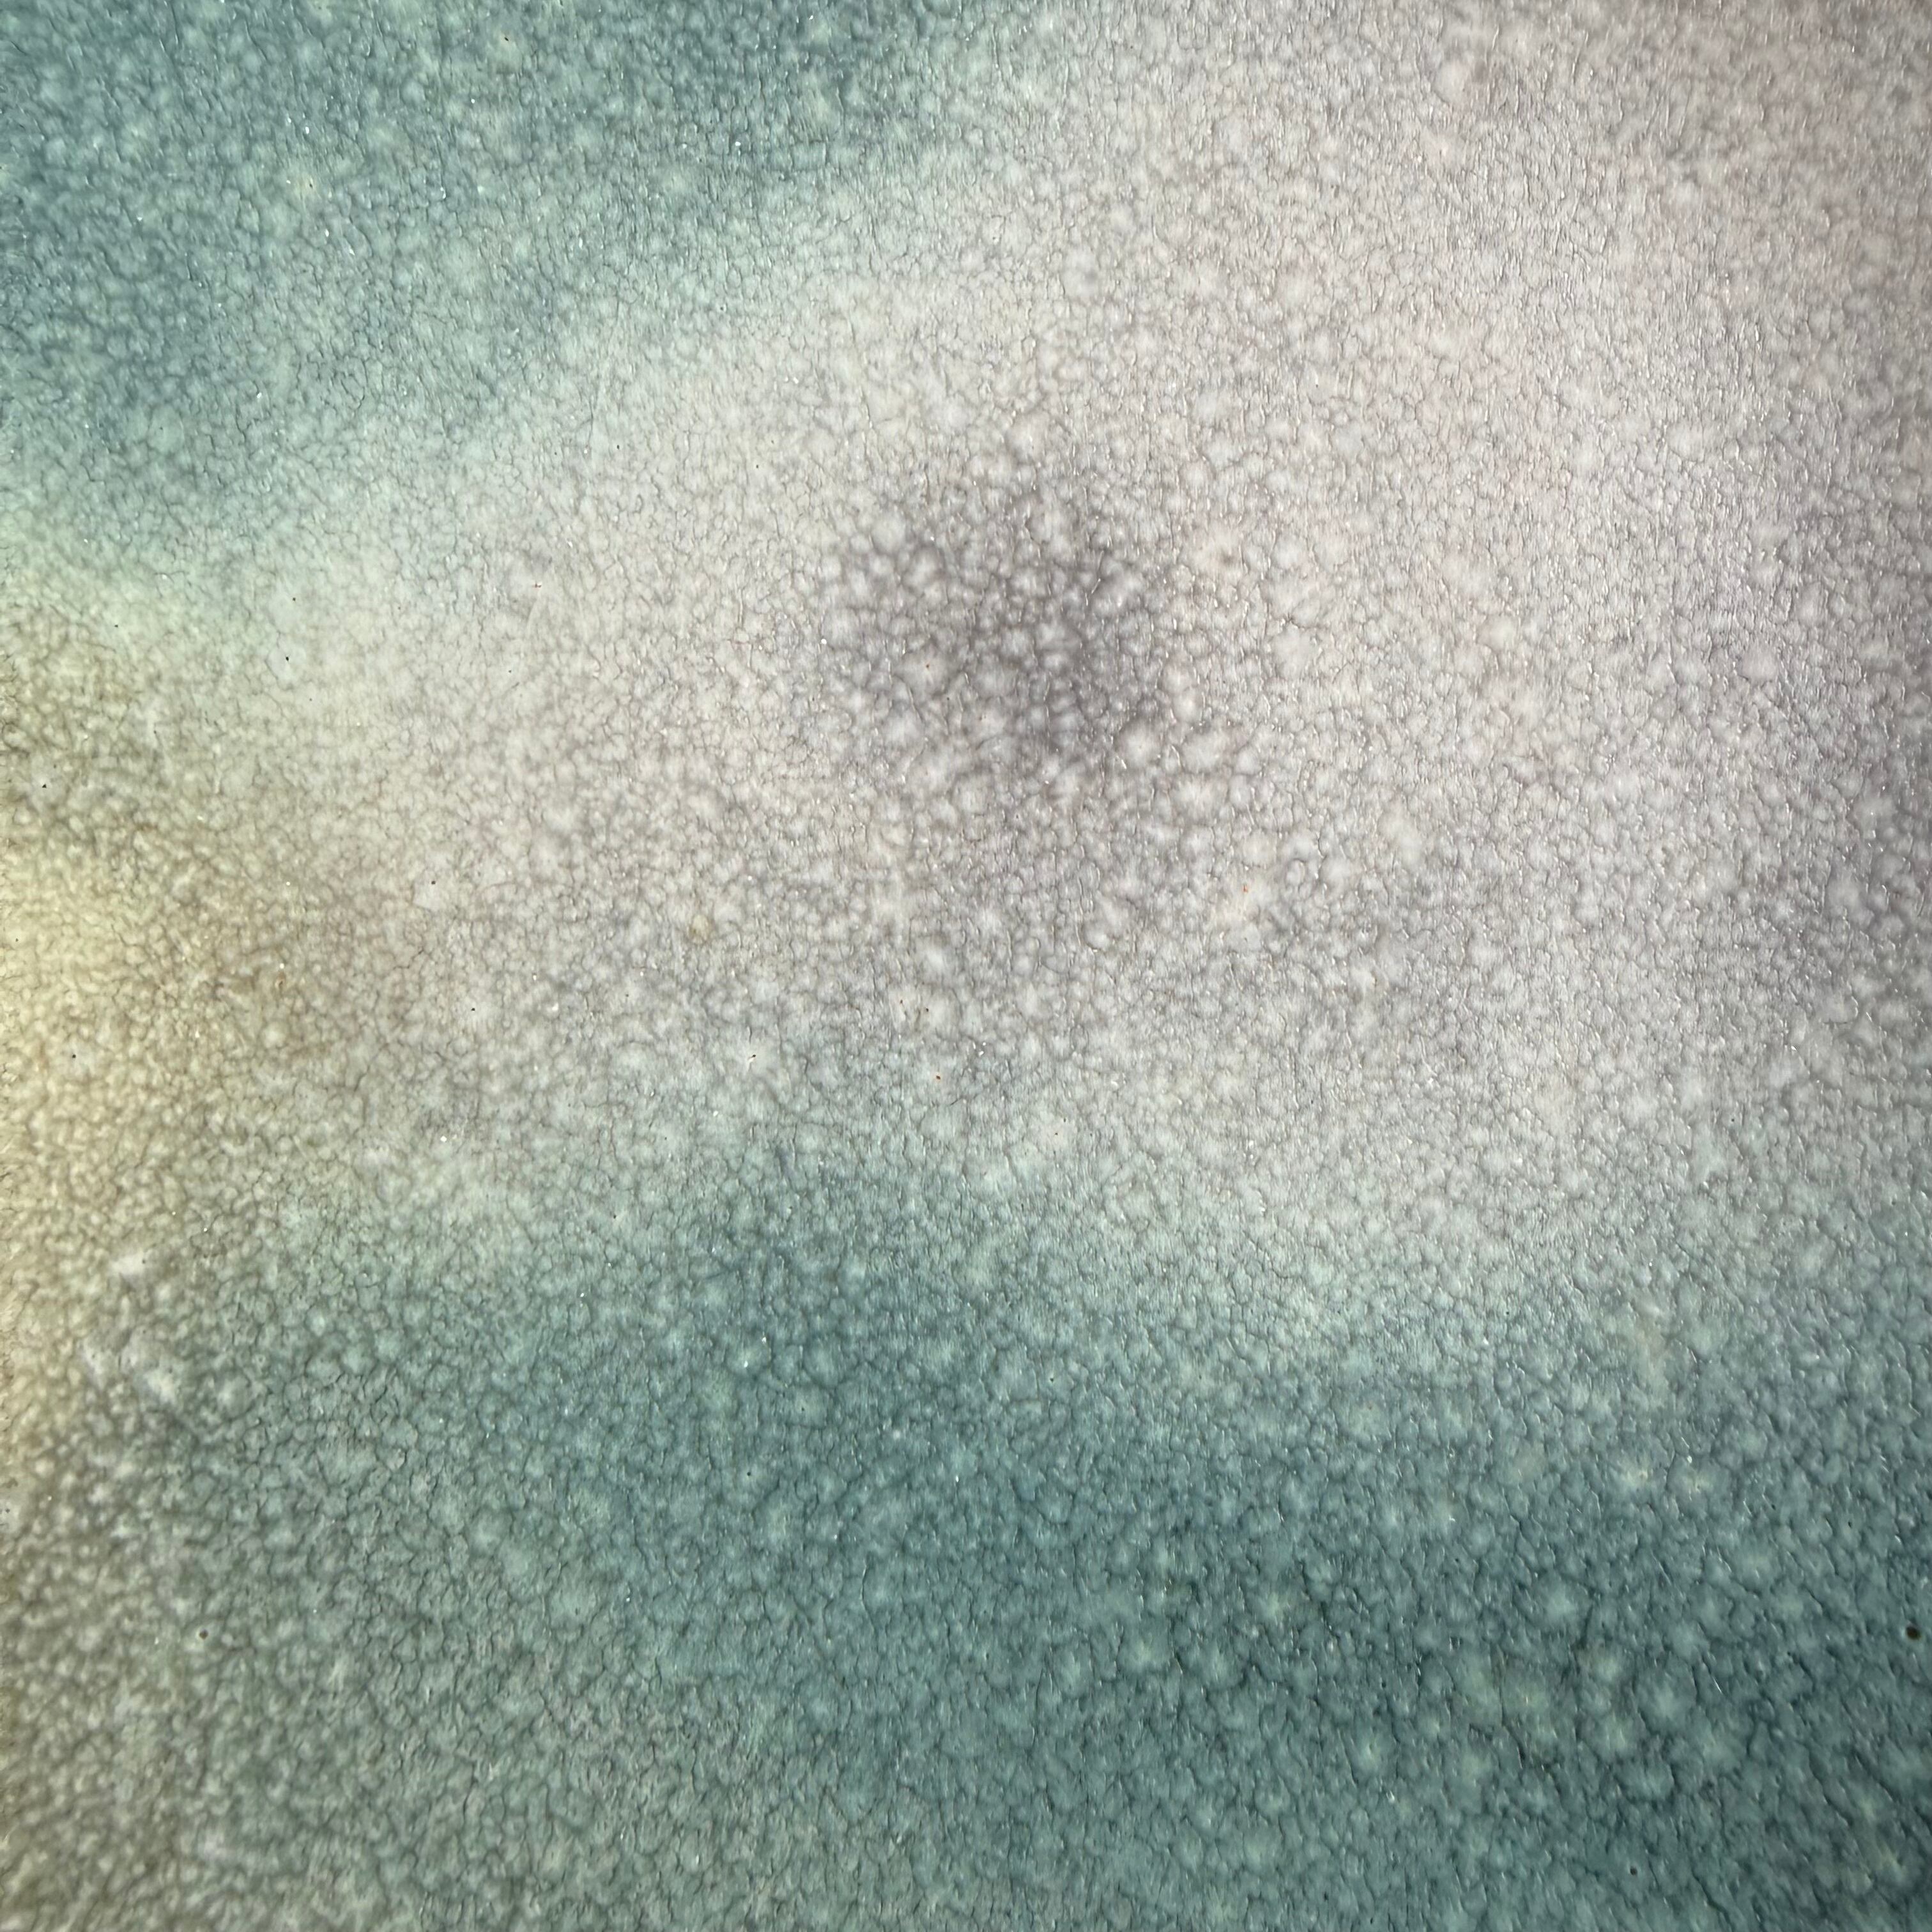

1/9
坂本り菜 1-1
¥6,050 税込
残り1点
なら 手数料無料で 月々¥2,010から
別途送料がかかります。送料を確認する
坂本り菜
サイズ:
直径21cm
高さ4cm
素材:
半磁器
*一つ一つ手作りの為個体差がございます
予めご了承ください。
*陶器(土物)は電子レンジ、食洗機をおすすめいたしません。
ご自身の判断でご使用くださいませ。
責任は負いかねます。
-
送料・配送方法について
-
お支払い方法について
¥6,050 税込
最近チェックした商品
同じカテゴリの商品
その他の商品
CATEGORY